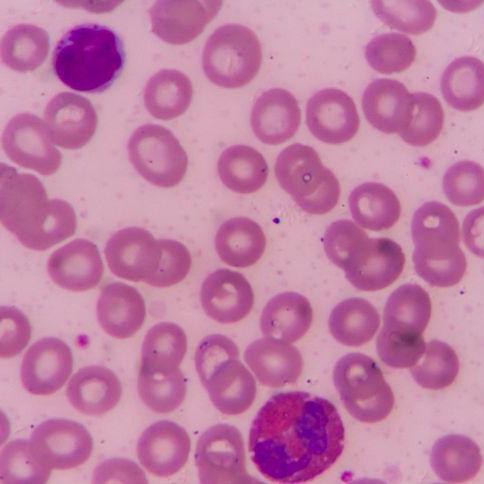

高等教育领域数字化综合服务平台

华中科技大学
教育部
- 74 高校采购信息
- 3294 科技成果项目
- 0 创新创业项目
- 0 高校项目需求
 成果领域
成果领域

信号探测器
基于超材料的太赫兹单谱信号探测器及其制备方法
合作:
白细胞分割
一种基于支持向量机的白细胞图像精确分割方法与系统
合作:

康复机器人
一种便携式二自由度腕关节康复机器人
合作:

图像恢复
一种弱小目标图像的自适应恢复增强方法
合作:

信号探测器
基于超材料的肖特基型远红外多谱信号探测器和制备方法
合作:

激光扫描
一种三维激光扫描方法及装置
合作:

无线通信
一种 MIMO 无线通信非相干酉空时调制的对跖解调方法及对跖 解调器
合作:

镜片成像
一种镜片成像装置及方法
合作:

信号探测器
基于超材料的肖特基型远红外多谱信号探测器和制备方法
合作:

人流量统计
一种基于时空上下文的人流量统计方法
合作:






